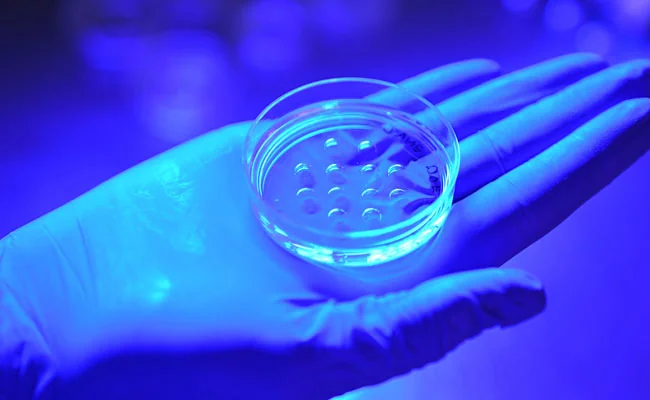

But for those who want to enter this field, the question is often: where do I start?
This is where World Embryology Skills and Training (WEST) comes in. Our intensive 3-month hands-on program is designed to bridge the gap between academic learning and real-world IVF practice. Students are trained in every aspect of embryology from oocyte handling and sperm preparation, embryo culture, vitrification, quality control to ICSI, and biopsy.
Under the guidance of passionate and experienced embryologists, students gain the confidence, precision, and technical competence needed to succeed in a clinical embryology lab anywhere in the world. If you've ever wanted a career that makes a real difference, one that combines science, purpose, and heart, embryology may be calling you. And we'd be honored to help you answer that call.


What Does an Embryologist Do?
Embryologists play a vital role in helping create families through assisted reproductive technologies like in vitro fertilization (IVF). They are specialized scientists who have scientific skill, steady hands, ability to work under pressure and emotional intelligence. They work behind the scenes in fertility clinics, handling eggs, sperm, and embryos to assist patients struggling with infertility.
On any given day, an embryologist might fertilize eggs (combining eggs and sperm in the lab), perform micromanipulation techniques like ICSI (injecting a single sperm into an egg), monitor embryo development under a microscope, and prepare embryos for transfer to the patient's uterus. They also handle cryopreservation (freezing embryos or eggs via vitrification) and perform embryo biopsies for genetic testing. In addition to these technical tasks, embryologists keep detailed records, maintain strict lab quality control, and often interact with doctors, nurses, and patients to coordinate the IVF process.
While much of their work is in the lab, embryologists understand the human impact of their job. They know that each embryo they culture represents a potential future child. The most rewarding part of the job is seeing patients return to the clinic with a healthy baby, knowing their lab work helped make that new life possible. Embryologists combine scientific precision with compassion, playing a crucial role in turning the dream of parenthood into reality.
Why Become an Embryologist?
Embryology can be an incredibly rewarding and dynamic career. Each day in an IVF lab brings new challenges and the opportunity to help people overcome infertility. Embryologists often don't mind the early or long hours because they're excited to check on overnight fertilization results or find out which patients got pregnant. Knowing you had a hand in creating a successful pregnancy, and ultimately a healthy baby, is a unique and fulfilling feeling that keeps embryologists passionate about their work.
Beyond the personal rewards, the career outlook for embryologists is very promising. There is a global shortage of trained embryologists, even as demand for fertility treatments continues to rise. Many IVF clinics are expanding, insurance has become mandated in many states and a wave of senior embryologists and lab directors are nearing retirement, creating a need for a new generation of specialists. This high demand means job opportunities are plentiful. Clinics often struggle to find qualified embryologists and are eager to hire those with the right training.
Job growth is strong as well. In the United States, employment of embryologists (often categorized under medical scientists or clinical laboratory professionals) is expected to grow faster than average. One estimate projected a ~17% growth in embryologist job openings from 2018 to 2028, reflecting the surge in IVF services. For new graduates, this translates into a high likelihood of finding work quickly after training. At WEST, 90% of its embryology graduates secure jobs within 3-6 months of finishing the course.
Finally, embryologists are well-compensated for their expertise. Salaries vary by region and experience, but are generally competitive. Salaries increase rapidly as clinical training is completed. Combined with the meaningful nature of the work, it's easy to see why embryology is an attractive career for those interested in science and helping others.

Steps to Become an Embryologist
Becoming an embryologist typically involves obtaining a strong education in the biological sciences followed by specialized training in embryology techniques. Below are the key steps to enter this field:
1. Earn a Bachelor's Degree in a Life Science
A bachelor's degree is the minimum education required to become an embryologist. Common majors for aspiring embryologists include Biology, Physiology, Biotechnology, Genetics, Biochemistry, Molecular Biology, Animal Science, or Reproductive Physiology. During college, take courses in cell biology, developmental biology, genetics, reproductive physiology, and lab techniques, all of which build knowledge you'll use in an embryology lab. Most embryology training programs and employers will expect you to have a B.S. in a biological science. Aim to maintain a strong GPA and seek out professors who work in related fields; their mentorship and references may help when you take the next steps.
2. Gain Laboratory Experience
Hands-on lab skills are essential for embryologists, so it's important to get as much laboratory experience during or after your undergraduate studies as possible. Take advantage of any opportunity to work in a lab setting - this could mean doing an undergraduate research project, working as a lab assistant for a professor, or pursuing a summer internship at a research institute or biotech company. If your university has a reproductive biology lab or collaboration with a fertility clinic, try to get involved, even if you have to volunteer. If you can't directly work with human embryos as a student, experience with cell culture, microscopy, or animal reproductive technology can be very valuable.
Not only will these experiences sharpen your practical skills (such as handling specimens, using microscopes, and maintaining sterile technique), they will also strengthen your résumé for future job or grad school applications. Many employers and programs look for candidates who have gone beyond coursework and demonstrated real lab proficiency. Plus, lab internships or research can help you decide if you enjoy the daily work of science - you might discover, for example, that you love working at the bench and are even more motivated to become an embryologist. The more lab experience the trainees have, the quicker they are hired. However, some trainees get hired with little to no lab experience (a great personality and interview goes a long way!).


3. Consider Advanced Degrees or Specialized Training
After earning your bachelor's, you have a couple of paths to further qualify yourself as an embryologist. One route is to pursue an advanced degree, such as a master's in clinical embryology, reproductive biology, or a related field. Some universities (for instance, in the UK, Australia, or the US) offer one- or two-year Master's programs in embryology or assisted reproduction. These programs provide in-depth theoretical knowledge and sometimes some lab exposure. However, a master's or Ph.D. is not required to work as an embryologist in a clinic, although it is required to be a lab director. In fact, many embryologists do not have a graduate degree; they enter the profession with a bachelor's degree and learn through intensive training and on-the-job experience.
The alternative (and often faster) route is to enroll in a specialized embryology training program, such as WEST, that focuses on practical, hands-on skills. Historically, new embryologists were trained on the job over several years, or they came from animal IVF labs, because formal training programs were non-existent. Today, the field is recognizing the need for dedicated training courses. For example, WEST offers a comprehensive 3-month Embryologist Training Course for aspiring clinical embryologists with little or no prior lab experience. This full-time program over 11 weeks, immerses students in all aspects of IVF lab work, totaling over 440 hours of hands-on training in techniques like egg handling, fertilization, embryo culture, ICSI, embryo grading, biopsy, and vitrification.
When choosing your path, consider your learning style, time, and resources. A formal master's degree will give you a deep academic understanding and may open doors to research roles, but it can take 1-2 years (and provide limited hands-on IVF experience). A focused training course or certificate program can get you lab-ready faster, with an emphasis on practical skills. Some students even do both - for example, getting a master's and then taking a short intensive IVF lab course.
4. Land an Entry-Level Embryologist Position
With your education and training in hand, the final step is to secure a job in the field. Entry-level roles may be titled "Junior Embryologist", "Embryology Lab Technician", or "Trainee Embryologist". During the WEST program, you have assistance in finding openings, resume writing and interview skills. When starting out, be prepared to continue learning on the job. Embryology labs often have a structured training progression for new hires: you might begin by observing and handling basic tasks (like preparing culture media or data entry of lab records), then move on to assisting senior embryologists with procedures.
Many labs have new embryologists practice delicate techniques on animal embryos (e.g. mouse embryos) or unfertilized human eggs that are not used for treatment, to hone their skills before working on patient embryos. Over time, as you gain experience and prove your competence, you will take on more responsibilities - for example, fertilizing eggs, monitoring embryo development, performing cryopreservation, and eventually advanced procedures like embryo biopsy. Mentorship and gradual skill-building are essential; even a 3-month intensive course is followed by a period of real-world practice under supervision.
Early in your career, feedback and learning from senior embryologists will be incredibly valuable. Embryology is sometimes as much an art as it is a science. Subtle techniques and problem-solving skills are passed down from experienced mentors. Take advantage of any professional development opportunities your lab offers. Some embryologists choose to pursue certification to enhance their credentials. While not always mandatory, there are certifications such as the American Board of Bioanalysis (ABB) certifications for embryology lab professionals in the U.S., which some employers prefer.
Finally, as you gain experience, you can advance to senior roles. A Senior Embryologist might oversee the lab's daily operations, train junior staff, and perform the most complex procedures. With further experience (and often additional degrees or certifications), some embryologists move up to become IVF Laboratory Directors or Andrology/Embryology Supervisors. Career advancement in embryology often comes with increased responsibility, but also the reward of being a leader in this life-changing field.

Conclusion
Becoming an embryologist requires dedication, scientific curiosity, and hands-on training, but it offers an exciting and fulfilling career. You'll be at the cutting edge of reproductive medicine and make a direct impact on people's lives. By following the steps above, from getting a solid education in the sciences, to mastering IVF lab techniques, to continuously learning on the job, you can launch a successful embryology career. The need for skilled embryologists has never been greater, so if this path appeals to you, there's no better time to start. Consider reaching out to WEST or fertility clinics to shadow for a day, and take that first step toward becoming a professional embryologist.
FAQs About Becoming an Embryologist
What education is required to become an embryologist?
−At minimum, you will need a bachelor's degree in a life science field to become an embryologist. Common majors are Biology, Physiology, Animal Science, Chemistry, Biochemistry, Molecular Biology, Health Science, Genetics, and Reproductive Physiology. Typically, you need a major with 24 units of Chem and Bio courses including labs. This undergraduate degree provides the foundational knowledge in cell biology, genetics, and physiology needed for embryology work. Some embryologists choose to earn a master's or Ph.D. in reproductive science or related fields, but these advanced degrees are not strictly required for working in an IVF lab. The key is that you have a strong background in biology and laboratory techniques, which a bachelor's (plus any specialized training) should provide.
Do I need a PhD or MD to become an embryologist?
+No - a Ph.D. or medical degree is not required to work as an embryologist. In fact, most clinical embryologists are not medical doctors. They are scientists/technologists rather than physicians. The standard requirement is a bachelor's degree in a life science field, after which you gain specialized training in embryology. While some embryologists do have Ph.D. degrees (often those involved in research or academic roles), you can absolutely become an embryologist with just a bachelor's degree and the right lab training. Hands-on skills and experience in IVF procedures tend to be more important in this career than a doctorate. In summary, you do not need to go to medical school or get a Ph.D. to be an embryologist working in a fertility clinic.
How long does it take to become an embryologist?
+The timeline can vary: if you go straight into a focused training program (for example, a 3-month intensive embryology training course), you could be job-ready soon after college. Alternatively, if you pursue a master's degree, that might add ~2 more years of schooling. Many embryologists also spend some time (months to a year) in entry-level lab roles or internships to build experience. However, you may start working in an embryology lab in a junior capacity before that (while still training). The learning curve in the lab continues for at least a year or two as you master all the intricate skills. So, becoming fully proficient as an embryologist is not instant, think of it as a one-year clinical transition after taking a hands-on course or 2-4 years of practical training on the job. The good news is that throughout that period, you are progressing toward a well-defined and rewarding career.
Are embryologists in demand?
+Yes, embryologists are very much in demand. The field of IVF and assisted reproduction has expanded rapidly in recent years, and there is a known shortage of qualified embryologists in many regions. Fertility clinics often report difficulty hiring experienced embryology lab staff, because the supply hasn't kept up with the growing number of IVF clinics and patients. This trend is expected to continue as more people seek fertility treatments and insurance is now mandated in many states (CA has mandated IVF insurance as of Jan 2026). In the United States, job growth for embryologists is outpacing many other professions - estimates show double-digit percentage growth in demand (around 17% increase in jobs over a decade). For someone entering this field, that means you are likely to find job opportunities in a variety of locations. Nearly every major city (and many smaller regions) now has fertility centers, and new labs continue to open. The high demand also means that embryologists can often advance quickly and have some choice in where they work. In short, embryology offers strong job security and a positive outlook for the foreseeable future.
How much do embryologists earn?
+Embryologist salaries vary based on experience, location, and the type of employer, but they are generally quite competitive. In the U.S., the average salary for an embryologist is roughly $90 - 100,000 per year. Entry-level embryologists or trainees will start lower, perhaps in the $60k-$80k range, depending on the region and clinic. Many embryologists once fully trained will be earning over $100,000. In some high-cost areas or prestigious clinics, senior embryologists and lab supervisors can earn upwards of $200,000 annually. Keep in mind that salary figures may also reflect varying job titles - someone listed as an "embryologist" could be a lab director with decades of experience, whereas a "junior embryologist" will earn less. Overall, embryology is a well-paying career, and compensation tends to grow with your expertise. Many embryologists also find that the rewarding nature of the job (helping to create a family) is a significant non-monetary benefit that comes with the salary. Finding a lab team that works together well and supports each other in growth and development are typically prioritized as the money will come in time, but the happiness and comfort with your team are a special find.
What skills and qualities are important for an embryologist?
+Embryologists need a mix of technical skills and personal qualities to excel. On the technical side, strong laboratory skills are a must, this includes excellent hand-eye coordination and dexterity (for manipulating sperm and eggs under a microscope), attention to detail, and the ability to meticulously follow protocols. You should be very comfortable with microscopes and other lab equipment and have a good understanding of reproductive biology and embryo development. Problem-solving skills are also important, since embryologists must troubleshoot issues in the lab (for instance, if fertilization rates are low, or incubator malfunctions). On the personal side, embryologists benefit from being patient, resilient, and compassionate. IVF can be a high-pressure environment because patients are anxiously awaiting results, so embryologists must stay calm and focused. Ability to deal with stress and work under pressure is a must, as the expectation is, you will not make mistakes in the lab. Good communication and teamwork skills are valuable too. You'll be coordinating with physicians, nurses, and sometimes talking to patients. Importantly, a passion for helping others and an understanding of the emotional journey of infertility will make you a better embryologist. Traits like empathy, dedication, and the willingness to keep learning new techniques will serve you well in this ever-evolving field.
Why Choose World Embryology Skills and Training

Real IVF Lab Training
You'll work with the same tools and techniques used in clinical labs every day. The impressive 3000 SF lab facility has all types of equipment present in clinical IVF labs today. WEST has 10 micromanipulators, 15 stereozoom scopes, 6 compound scopes, 6 different types of incubators (including two time-lapse incubators), EMR and AI technologies.
Comprehensive Curriculum
Our program covers every essential embryology skill from start to finish including detailed lectures explaining the "WHY" behind everything we do.
Personal Mentorship
Small class sizes mean you get personalized guidance every step of the way with full access to plenty of lab equipment at all times.
Professional Certification
Earn a Certificate of Competency that demonstrates your readiness to work in the field. You can apply to take the exam for a provisional ELS/ALS license through AAB. Detailed competency assessments will help expedite your clinical training.
Passion for the Science
Led by a team that truly loves embryology and believes in every student's potential. Gina Cirimele And Debbie Venier are full-time trainers with 13 and 31 years of experience, respectively. They are both certified as Technical Supervisors through AAB.
Global Career Preparation
Graduates work in IVF centers across the U.S. and internationally.
Apply Now
Apply now to the World Embryology Skills and Training 3-Month Program to take your first step to becoming an embryologist. If you've ever dreamed of being part of something truly meaningful — helping people create families, working with the very beginnings of life, and mastering some of the most delicate and fascinating lab skills in science — then embryology might be the perfect career for you.
Becoming an embryologist doesn't just take knowledge — it takes passion, precision, and practice. And that's exactly what we teach at World Embryology Skills and Training. Our students train in a fully equipped IVF laboratory under the direct mentorship of experienced embryologists who love what they do (and love teaching it even more!).
